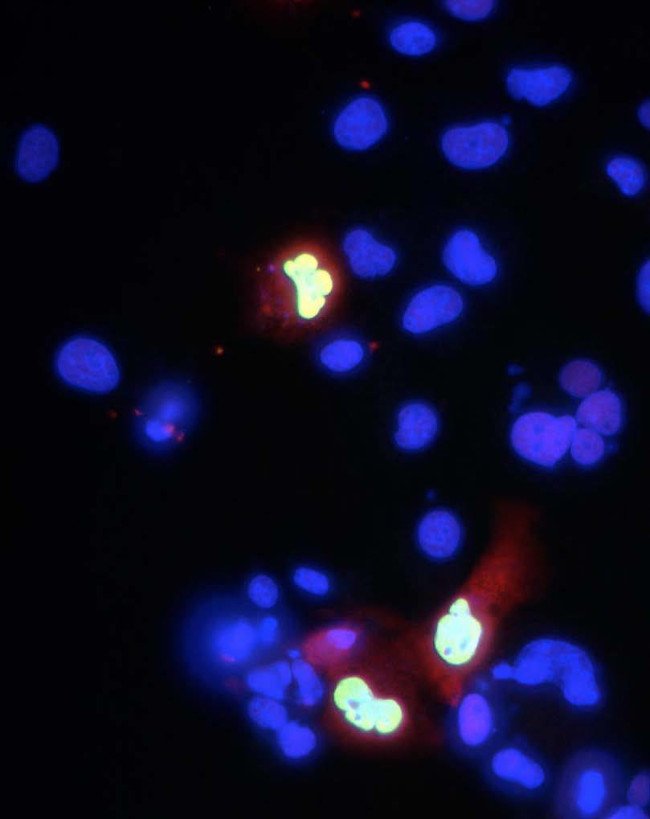
Co-Rest/RCOR1 Antibody in Immunocytochemistry (ICC/IF)
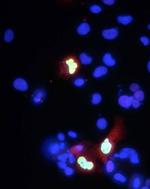
Co-Rest/RCOR1 Antibody in Immunocytochemistry (ICC/IF)

Search
Antibodies Inc
Co-Rest/RCOR1 Monoclonal Antibody (K72/8)
{{$productOrderCtrl.translations['antibody.pdp.commerceCard.promotion.promotions']}}
{{$productOrderCtrl.translations['antibody.pdp.commerceCard.promotion.viewpromo']}}
{{$productOrderCtrl.translations['antibody.pdp.commerceCard.promotion.promocode']}}: {{promo.promoCode}} {{promo.promoTitle}} {{promo.promoDescription}}. {{$productOrderCtrl.translations['antibody.pdp.commerceCard.promotion.learnmore']}}
产品信息
75-039
种属反应
宿主/亚型
分类
类型
克隆号
抗原
偶联物
形式
浓度
规格
纯化类型
保存液
内含物
保存条件
运输条件
产品详细信息
For maximum recovery of product, centrifuge the vial prior to removing the cap.
靶标信息
RCOR1 is a functional corepressor required for regulation of neural-specific gene expression. The RCOR gene encodes a functional corepressor required for regulation of neural-specific gene expression. The RCOR gene encodes a functional corepressor required for regulation of neural-specific gene expression.
仅用于科研。不用于诊断过程。未经明确授权不得转售。
篇参考文献 (0)
生物信息学
蛋白别名: KIAA0071; Protein CoREST; REST corepressor 1; REST corepressor 1-like; REST-interacting protein
基因别名: 5730409O11; 6720480E22Rik; AU042633; COREST; D12Wsu95e; KIAA0071; mKIAA0071; RCOR; RCOR1; Rocr1
UniProt ID: (Human) Q9UKL0, (Mouse) Q8CFE3
Entrez Gene ID: (Rat) 102554884, (Human) 23186, (Mouse) 217864